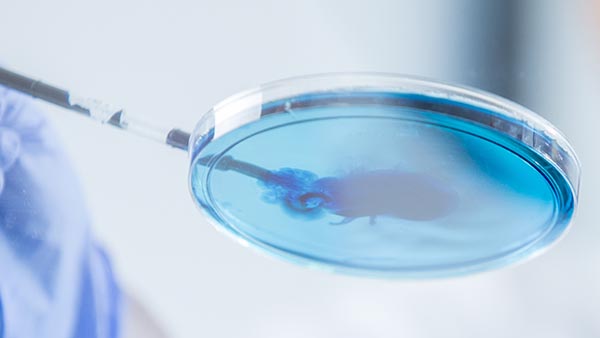
laboratory with a specimen dish

Our Community-Based Care Facility Is Centered on You
Exceptional care…right in your own backyard
Leading-edge therapies, innovative treatments, and exceptional care are available in your own neighborhood. We bring world-class care to you, delivered with the expertise and compassion that make UT Southwestern one of the top medical centers in the nation.
The Medical Center at Richardson/Plano is located on Waterview Parkway in Richardson, just two blocks north of the University of Texas at Dallas, making it convenient for patients in northwestern Dallas County and Collin County. Abundant free parking is adjacent to the building, which houses only UT Southwestern services.